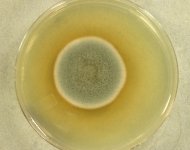
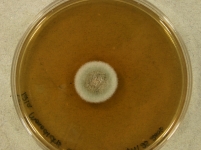

Search Details
| UAMH Number: | 10720 |
|---|---|
| Species Name: | Monodictys arctica |
| Type: | Monodictys arctica |
| Synonyms: | |
| Taxonomy: | FUNGI Ascomycota, Dothideomycetes, Pleosporales |
| Strain History: | M. Day -> Currah, R.S. (121) -> UAMH |
| Substrate: | roots of Saxifraga oppositifolia | Location: | CANADA Nunavut, Ellesmere Island, Alexandra Fjord (GEO: 78.884,-75.917) |
| Isolator: | M. Day |
| Isolation Date: | 2001-01-17 |
| Date Received: | 2006-08-24 |
| Characters: | MYCORRHIZAE dark septate endophyte (DSE) - Day MJ, Gibas CFC, Fujimura KE, Egger KE, Currah RS, Mycotaxon 98:261-272, 2006 // SYSTEMATICS/ TAXONOMY description of a dark septate endophyte with affinity to Leptosphaeria - (Click for publications citing UAMH 10720) |
| Compounds: | |
| Cross Reference: | |
| Collections: | Living Strains; Dried Herbarium Material |
| Pathogenic Potential: | Human: no | Animal: no | Plant: no |
| Biosafety Risk Group: | RG1 (check the PHAC ePATHogen Risk Group Database for updates) |
| Regulatory Requirements: | No restrictions for Canadian requesters. International requesters must provide all legally required importation documentation prior to shipment. Plant pathogenicity status may be verified by using the USDA Agricultural Research Service (ARS) Fungal Database |
| MycoBank ID: | 510336 |
| Sequences: | >UAMH10720_EU686519 AAAGATTAAGCCATGCATGTCTAAGTATAAGCAATTATACCGTGAAACTGCGAATGGCTCATTAAATCAGTTATCGTTTATTTGATAGTACCTTACTACTTGGATAACCGTGGTAATTCTAGAGCTAATACATGCTTAAAACCCCAACTTCGGGAGGGGTGTATTTATTAGATAAAAAACCAACGCCCTTCGGGGCTTCTTGGTGATTCATGATAACTTTACGGATCGCATGGCCTTGCGCCGGCGACGGTTCATTCAAATTTCTGCCCTATCAACTTTCGATGGTAAGGTATTGGCTTACCATGGTTTCAACGGGTAACGGGGAATTAGGGTTCGATTCCGGAGAGGGAGCCTGAGAAACGGCTACCACATCCAAGGAAGGCAGCAGGCGCGCAAATTACCCAATCCCGACACGGGGAGGTAGTGACAATAAATACTGATACAGGGCTCTTTTGGGTCTTGTAATTGGAATGAGTACAATTTAAACCTCTTAACGAGGAACAATTGGAGGGCAAGTCTGGTGCCAGCAGCCGCGGTAATTCCAGCTCCAATAGCGTATATTAAAGTTGTTGCAGTTAAAAAGCTCGTAGTTGAAACTTGGGTCTGGCTGGCAGGTCCGCCTCACCGCGTGTACTTGTCCGGCCGGGCCTTCCTTCTGGAGAACCTCATGCCCTTCACTGGGCGTGTTGGGGACCAGGACTTTTACTTTGAAAAAATTAGAGTGTTCAAAGCAGGCCTTTGCTCGAATACGTTAGCATGGAATAATAGAATAGGACGTGCGGTCCTATTTTGTTGGTTTCTAGGACCGCCGTAATGATTAATAGGGACAGTCGGGGGCATCAGTATTCAATTGTCAGAGGTGAAATTCTTGGATTTATTGAAGACTAACTACTGCGAAAGCATTTGCCAAGGATGTTTTCATTAATCAGTGAACGAAAGTTAGGGGATCGAAGACGATCAGATACCGTCGTAGTCTTAACCGTAAACTATGCCGACTAGGGATCGGGCGATGTTCTTTTTCTGACTCGCTCGGCACCTTACGAGAAATCAAAGTTTTTGGGTTCTGGGGGGAGTATGGTCGCAAGGCTGAAACTTAAAGAAATTGACGGAAGGGCACCACCAGGCGTGGAGCCTGCGGCTTAATTTGACTCAACACGGGGAAACTCACCAGGTCCAGATGAAATAAGGATTGACAGATTGAGAGCTCTTTCTTGATTTTTCAGGTGGTGGTGCATGGCCGTTCTTAGTTGGTGGAGTGATTTGTCTGCTTAATTGCGATAACGAACGAGACCTTAACCTGCTAAATAGCCAGGCTAGCTTTGGCTGGTCGCCGGCTTCTTAGAGGGACTATCGGCTCAAGCCGATGGAAGTTTGAGGCAATAACAGGTCTGTGATGCCCTTAGATGTTCTGGGCCGCACGCGCGCTACACTGACAGAGCCAACGAGTTCTTCACCTTGACCGAAAGGTCTGGGTAATCTTGTTAAACTCTGTCGTGCTGGGGGATAGAGCATTGCAATTATTGCTCTTCAACGAGGAATGCCTAGTAAGCGCGTGTCATCAGCATGCGTTGATTACGTCCCTGCCCTTTGTACACACCGCCCGTCGCTACTACCGATTGAATGGCTCAGTGAGGCCTTCGGACTGGCTCGGGGAGGTTGGCAACGACCACCCCGAGCCGGAAAGTTCGTCAAACTCGGTCATTTAGAGGAAGTAAAAGTCGTAACAAGGTTTCCGT >UAMH10720_EU686521_ITS GCTCGGGGAGGTTGGCAACGACCACCCCGAGCCGGAAAGTTCGTCAAACTCGGTCATTTAGAGGAAGTAAAAGTCGTAACAAGGTTTCCGTAGGTGAACCTGCGGAAGGATCATTAAACATCATCGGGGAGTTGGATCCAGATTGTGGGGCTTCGGTCTCGCTTTCTGCCCTTCTCTTACTGATTATACCCATGTCTTTTGCGTACTATTTGTTTCCTTGGTGGGCTTGCCTGCCGATAGGACATCATTAAACCTTTTGTAATTGCAGTCAGCGTCAGAAAAACATAATAATTACAACTTTCAACAACGGATCTCTTGGTTCTGGCATCGATGAAGAACGCAGCGAAATGCGATAAGTAGTGTGAATTGCAGAATTCAGTGAATCATCGAATCTTTGAACGCACATTGCGCCCCTTGGTATTCCATGGGGCATGCCTGTTCGAGCGTCATTTGTACCCTCAAGCTCTGCTTGGTGTTGGGTGTTTGTCCCGCTTTTCGCGTGGACTCGCCTTAAAACAATTGGCAGCCGGCATATTGGCCTGGAGCGCAGCACATTTTGCGCCTCTTGTCATGATTGTTGGCATCCATCAAGACTATTTT |
IMAGES: